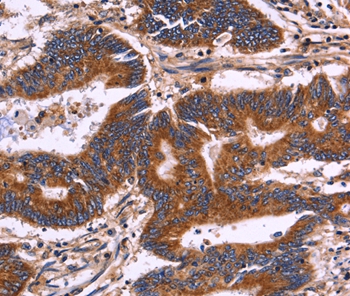
产品细节图片1

相关产品推荐更多 >
万千商家帮你免费找货
0 人在求购买到急需产品
- 详细信息
- 文献和实验
- 技术资料
- 免疫原:
Fusion protein corresponding to a region derived from internal residues of human killer cell immunoglobulin-like receptor, two domains, long cytoplasmic tail, 3/1/4/ short cytoplasmic tail, 4
- 形态:
liquid
- 保存条件:
Store at -20˚C
- 克隆性:
Polyclonal
- 适应物种:
Human
- 保质期:
12 months
- 抗原来源:
Rabbit
- 供应商:
南京赛戈巍生物科技有限公司
- 宿主:
Rabbit
- 应用范围:
IHC
- 靶点:
Uniprot:P43628
- 抗体英文名:
KIR2DL3/1/4/S4 Antibody
- 规格:
50ul/100ul
配方:Rabbit IgG in pH7.3 PBS, 0.05% NaN3, 50% Glycerol.
应用详情:Immunohistochemistry: 1:50-1:100
图片:
Immunohistochemical analysis of paraffin-embedded Human colon cancer tissue using #36321 at dilution 1/30.
,

Immunohistochemical analysis of paraffin-embedded Human thyroid cancer tissue using #36321 at dilution 1/30.
风险提示:丁香通仅作为第三方平台,为商家信息发布提供平台空间。用户咨询产品时请注意保护个人信息及财产安全,合理判断,谨慎选购商品,商家和用户对交易行为负责。对于医疗器械类产品,请先查证核实企业经营资质和医疗器械产品注册证情况。
文献和实验x-S的质控图是检验主管技师考试要求掌握的内容,医学教育网搜集整理相关内容供大家参考。 后来Henry和Segalove对X-R质控图进行了修改,他们以20次质控物的单次测定结果,计算其x及标准差(s),以x±2S为警告限,以x±3S为失控限,这也就是现在广为应用的Levey—Jennings质控图,从质控图的体系来说,它属于单值质控图中的x-S质控图。这个质控图适用于质控数据取得需要较长周期或费用昂贵时,其方法比较简单,易于推广。实际上这两种质控图的检定力是不同的,原
Henry和Segalove对X-R质控图进行了修改,他们以20次质控物的单次测定结果,计算其x及标准差(s),以x±2S为警告限,以x±3S为失控限,这也就是现在广为应用的Levey-Jennings质控图,从质控图的体系来说,它属于单值质控图中的x-S质控图。这个质控图适用于质控数据取得需要较长周期或费用昂贵时,其方法比较简单,易于推广。实际上这两种质控图的检定力是不同的,原Levey-Jennings质控图优于用单次测定结果绘制的医学`教育网搜集整理质控图,且提供了更多的质量
X-S图法由于它只需要单一浓度的未定值血清,绘图方法简单易懂,有较为成熟的理论和实际经验。因此,成为国内外目前采用最广泛的一种常规室内质量控制方法。一般步骤和具体做法如下: ⒈最佳条件和常规条件下的变异的测定及计算 选择含量均匀、稳定性良好的未定值质控血清,在“最佳条件”,对该批血清反复测定(至少20份),计算出20个结果的X、S和CV,此CV即为最佳条件下的变异(optimal condition variance,OCV)。取测过OCV的质量
技术资料暂无技术资料 索取技术资料





![PFKFB3 Rabbit Polyclonal Antibody[53922]](https://img1.dxycdn.com/p/s14/2025/0922/498/0460884283108299691.jpg!wh200)
![KIRREL2 Antibody[36653]](https://img1.dxycdn.com/p/s14/2025/0922/359/6146153295428599691.jpg!wh200)
![RNF167 Antibody[45963]](https://img1.dxycdn.com/p/s14/2025/0922/568/0046652811090600791.jpg!wh200)
![ITGA4 Mouse mAb[63795]](https://img1.dxycdn.com/p/s14/2025/0922/632/2321321568067599691.jpg!wh200)
